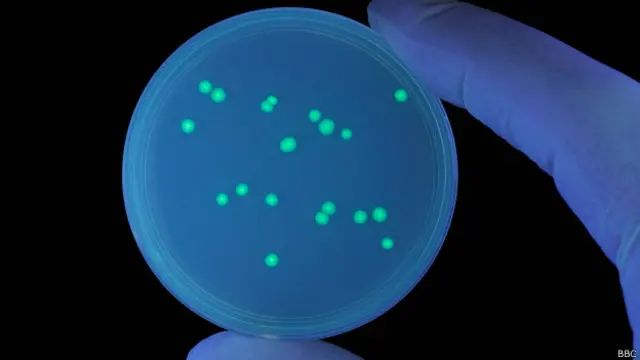
Vida de las nubes

¿Se puede vivir en el cielo?
Cuando miramos hacia el cielo, vemos un vasto océano de aire, en el que danzan aves e insectos pero, ¿hasta qué altura habrá seres vivos y cómo sobreviven? Un equipo de científicos voló a investigar.





Cuando miramos hacia el cielo, vemos un vasto océano de aire, en el que danzan aves e insectos pero, ¿hasta qué altura habrá seres vivos y cómo sobreviven? Un equipo de científicos voló a investigar.